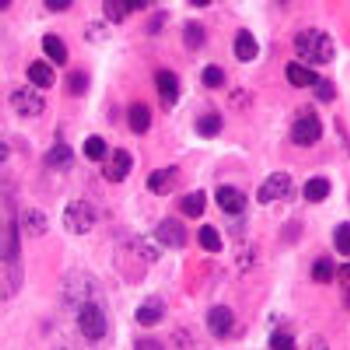

Inhibiting BRAF and MEK at the same time improves progression-free survival (PFS) more so than BRAF inhibition alone in patients with BRAF V600 mutation-positive metastatic melanoma, according to results of a phase III placebo-controlled trial.

Your AI-Trained Oncology Knowledge Connection!


Inhibiting BRAF and MEK at the same time improves progression-free survival (PFS) more so than BRAF inhibition alone in patients with BRAF V600 mutation-positive metastatic melanoma, according to results of a phase III placebo-controlled trial.

In patients with advanced gastric cancer expressing PD-L1, pembrolizumab (Keytruda) has robust antitumor activity and an acceptable safety profile

Treatment with nivolumab (Opdivo) demonstrated superior objective response rates (ORR) and longer durations of response compared with chemotherapy in a phase III trial of patients with previously treated advanced metastatic melanoma, reported Jeffrey Weber, MD, at the 2014 ESMO Congress.

Dual HER2 blockade with pertuzumab and trastuzumab plus chemotherapy for the treatment of HER2-positive metastatic breast cancer improved median OS by almost 16 months over standard first-line therapy.

Cediranib improved response rate and median PFS when added to conventional chemotherapy in a phase II study of patients with relapsed or metastatic cervical cancer.

Vintafolide in combination with docetaxel showed improvements in PFS and OS compared with single-agent docetaxel as second-line treatment of patients with folate receptor–positive NSCLC.

Dovitinib, an investigational oral tyrosine kinase inhibitor (TKI), demonstrated a "manageable" safety profile while controlling disease in about half of patients with advanced gastrointestinal stromal tumor (GIST) who had discontinued treatment with imatinib due to disease progression or intolerance

The combination of letrozole with either the CDK4/6 inhibitor LEE011 or the PI3 kinase Inhibitor BYL719 demonstrated clinical activity for women with ER-positive, HER2-negative breast cancer.

A novel HER2-derived peptide vaccine designed to stimulate CD8+ cytotoxic T-lymphocytes reduced the rate of breast cancer recurrence and proved safe and well tolerated in the adjuvant setting.

The PARP inhibitor veliparib exhibits antitumor activity and is safe and tolerable on a continuous dosing schedule when used for the treatment of patients with BRCA-positive and BRCA-wild type tumors.

Long-term follow-up of a phase III clinical trial shows strong trends toward a greater likelihood of resuming menses and becoming pregnant when a luteinizing hormone-releasing hormone (LH-RH) analog is administered with chemotherapy in patients with breast cancer

Breast conserving therapy (BCT) improves overall survival compared with other local treatments in patients with stage I breast cancer, according to an examination of the National Cancer Database (NCDB).

Administering carfilzomib once weekly in combination with dexamethasone is safe, with few ≥3 adverse events, and has significant antitumor activity in the treatment of patients with relapsed or refractory multiple myeloma.
Daratumumab, a fully human IgG1k monoclonal antibody that targets CD38, has demonstrated promising activity as monotherapy in patients with relapsed/refractory multiple myeloma

As a first-line treatment, crizotinib (Xalkori) improved progression-free survival (PFS) and objective response rate (ORR) compared with standard chemotherapy in patients with advanced ALK-positive non–small cell lung cancer (NSCLC).

The anti-PD-L1 antibody MEDI4736 has early and durable activity in patients with non–small cell lung cancer (NSCLC) of both squamous and nonsquamous histology, with higher objective response rates occurring in PD-L1–positive patients, according to results of an ongoing phase I study.

In the first pivotal phase III study of a Janus-associated kinase (JAK) inhibitor for the treatment of polycythemia vera (PV), ruxolitinib (Jakafi) was superior to best available therapy (BAT) in maintaining control of hematocrit without the need for phlebotomy and in reducing spleen size in patients with an inadequate response to or intolerance of hydroxyurea.

Cabozantinib added to erlotinib has antitumor activity in heavily pretreated patients with EGFR-positive non–small cell lung cancer (NSCLC) whose disease progressed on erlotinib alone, according to the results of a phase II trial presented at the 2014 ASCO Annual Meeting.

Continuing EGFR inhibition beyond progression with afatinib plus paclitaxel significantly improved PFS and ORR compared with chemotherapy alone in patients with heavily pretreated metastatic NSCLC.

The anti-PD-1 humanized antibody pembrolizumab has robust antitumor activity as a first-line treatment for patients with advanced PD-L1-positive NSCLC.

Adding necitumumab to standard of care with gemcitabine-cisplatin significantly improves survival compared with chemotherapy alone as first-line treatment in patients with stage IV non–small-cell lung cancer of squamous histology.

High tumor expression of the protein PD-L1 is independently associated with shorter OS in patients with mRCC receiving treatment with VEGF-targeted therapy.

Two new combinations demonstrated activity in refractory or advanced, previously untreated urothelial carcinoma in phase II evaluations.

Survival, measured as either disease-specific survival or relative conditional survival, has not improved for patients with metastatic urothelial carcinoma despite increasing use of second-line therapies with no formal indication in this setting.

Patients with metastatic castration-resistant prostate cancer (mCRPC) who have detectable serum androgen levels despite treatment with ketoconazole experience prostate-specific antigen (PSA) response to subsequent abiraterone acetate

Extended follow-up of patients with castration-resistant prostate cancer (CRPC) and bone metastases randomized to radium-223 dichloride (Xofigo) in the phase III ALSYMPCA study revealed a continued low incidence of myelosuppression and no association with secondary malignancies.

Postneoadjuvant bisphosphonate therapy in women with residual invasive disease following chemotherapy for primary breast cancer does not improve clinical outcomes, according to an interim analysis of a large phase III clinical trial presented at the 2013 San Antonio Breast Cancer Symposium.

Antiangiogenic therapy with ramucirumab, an investigational agent that binds to VEGFR-2, added to first-line docetaxel failed to delay the progression of HER2-negative metastatic breast cancer.

The combination of everolimus, trastuzumab, and vinorelbine, as given in the BOLERO-3 trial in patients with pretreated HER2-positive advanced breast cancer, is adequately tolerated, and adverse events are manageable.

In women with metastatic breast cancer that responds to frontline chemotherapy, locoregional treatment (LRT) of the primary tumor and axillary nodes does not produce an increase in overall survival (OS),